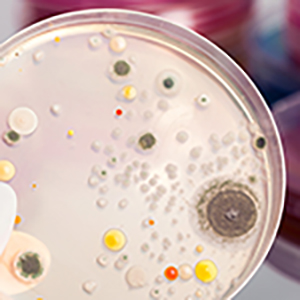

Careers in Science & Mathematics
Science jobs are in demand.
Every year, the demand for science graduates continues to grow. Dozens of industries are experiencing rapid growth in science, technology, engineering and mathematics (STEM) related jobs. Sustainability careers are also on the rise and in high demand as we increasingly look to promote environmental protection, social responsibility, and profitability.
U.S.News ranks in-demand jobs ranging from dentist to teacher.
Sustainability Degree: Information for those interested in sustainability careers.
STEM Careers: Over 100 career profiles that introduce science, technology, engineering, & math.
Face 2 Face with Career Services
Career Services works hard to provide all WSU students with the resources needed to prepare for, find, interview for, and gain employment. Every student should be exploring their site and taking advantage of their excellent opportunities. Greg Nielsen is a science career specialist in Career Services.